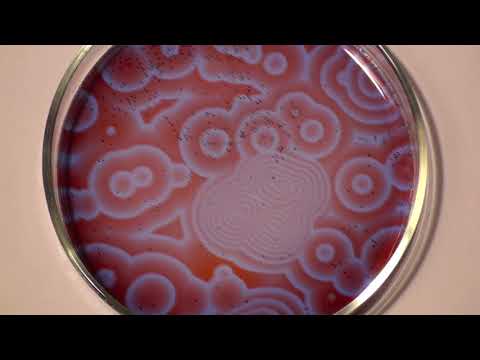
YouTube video

Bement Lab
88 posts

@BementLab
Transient contractile arrays. Part of the Center for Quantitative Cell Imaging (@UWCQCI) at UW-Madison. Tweets mostly by @ZacSwider and @AniMichaud1.

Light sheet imaging with @henryhetired and @spim revealed that these patterns were wide-spread and well-developed at merely 5hrs post-mRNA injection. This behavior was not seen with GAP-dead RGA or another cytokinetic GAP (p190RhoGAP).

Our latest pre-print is up on @bioRxiv! Here, @AniMichaud1 et al. identified Ect2 and RGA-3/4 as core components of cytokinetic cortical excitability. We also show that immature Xenopus oocytes are a powerful model for characterizing excitability. A 🧵... biorxiv.org/content/10.110…




